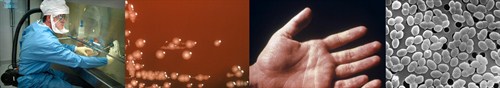
Banner for science

Enterobacter aerogenes is not only hard to pronounce, but it is also causing major problems in infection control and patient safety. Extensive laboratory testing has proven that Antimicrobial Copper continuously kills Enterobacter aerogenes and is safe to use.
Enterobacter aerogenes is a nosocomial and pathogenic bacterium that causes opportunistic infections. It is a Gram-negative rod shaped bacteria. E. aerogenes is generally found in the human gastrointestinal tract and does not generally cause disease in healthy individuals. It has been found to live in various wastes, hygienic chemicals, and soil.
Bacteria in healthcare settings are surviving on stainless steel and causing serious damage in the US Healthcare system. Annually $45 billion is spent on treating healthcare acquired infections. What is even worse is that 100,000 Americans die each year from all types of healthcare acquired infections. Addressing the hospital built environment could play a huge role in improving these tragic numbers.
The below chart were the results of testing per EPA approved protocols of Enterobacter aerogenes and Staphylococcus aureus on stainless steel versus Antimicrobial Copper.

Read more on the other bacterium that Antimicrobial Copper is registered to kill.
- E. coli O157:H7
- MRSA : Methicillin-Resistant Staphylococcus aureus
- VRE : Vancomycin-Resistant Enterococcus faecalis
- Pseudomonas aeruginosa

*Laboratory testing shows that, when cleaned regularly, antimicrobial copper surfaces kill greater than 99.9% of the following bacteria within 2 hours of exposure: MRSA, VRE, Staphylococcus aureus, Enterobacter aerogenes, Pseudomonas aeruginosa, and E. coli O157:H7. Antimicrobial copper surfaces are a supplement to and not a substitute for standard infection control practices and have been shown to reduce microbial contamination, but do not necessarily prevent cross contamination or infections; users must continue to follow all current infection control practices.
